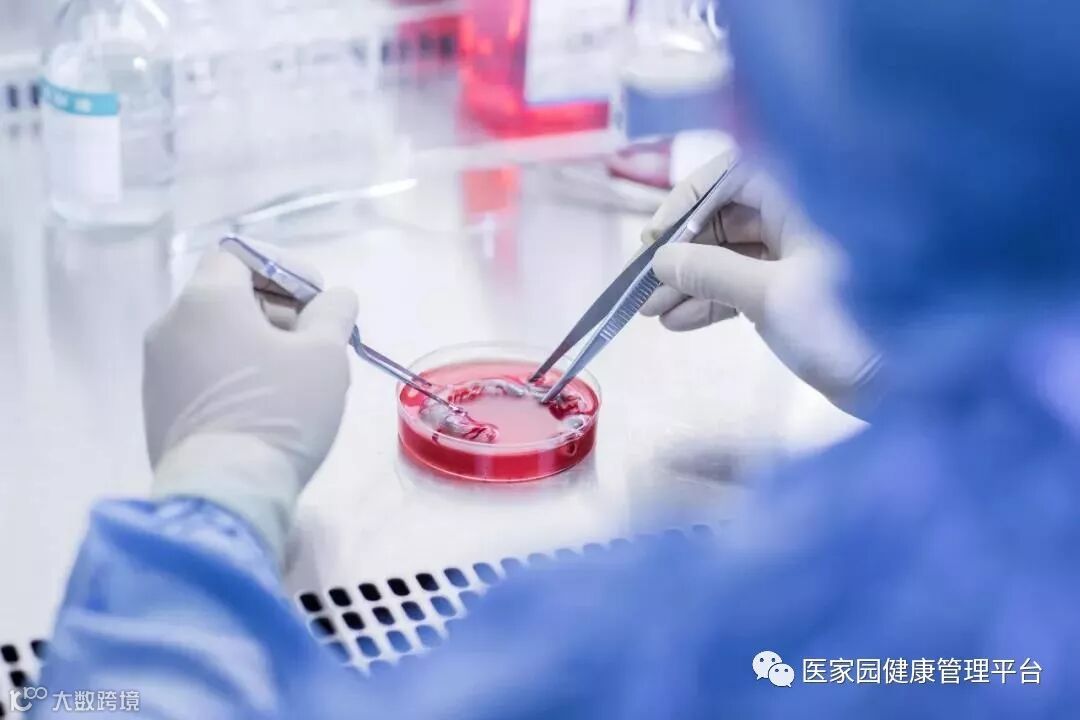

一、脐带间充质干细胞
脐带间充质干细胞(hUC-MSCs)是存在于脐带华通氏胶(Wharton’s jelly)和血管周围组织中的一种间充质干细胞。来源于脐带的间充质干细胞因其取材方便,无道德伦理争议,可获取的细胞数量多、增殖能力强、免疫调节作用大,分泌细胞生长因子的总量也非常高,便于扩增和传代,同时又没有配型、排异等问题,极其适合用于临床研究和应用,是间充质干细胞的理想来源。
二、脐带间充质干细胞的临床研究与应用
(一)国内相关研究
在中国临床试验注册中心注册的间充质干细胞相关临床试验超过70项,其中脐带间充质干细胞相关临床试验28项。
(二)脐带间充质干细胞临床应用研究案例
1、造血支持
脐带间充质干细胞联合造血干细胞移植可发挥强大的造血支持能力:改善骨髓造血微环境,促进造血干细胞的植入,显著加快移植后的造血重建,安全且并发症少。同时,适量的间充质干细胞在造血干细胞移植中,可以降低移植物抗宿主病的发生率和严重程度。

2、免疫系统疾病
科学家发现间充质干细胞具有调节免疫的作用,有着广泛的临床应用前景。
✔ 移植物抗宿主病
血液病患者接受同种异体造血干细胞移植术后,急性移植物抗宿主病(aGVHD)可导致高死亡率。
第三军医大学新桥医院为40例aGVHD患者施行他克莫司加甲氨蝶呤(MTX)+脐带间充质干细胞的抗GVHD治疗,相较仅接受他克莫司+MTX的常规治疗组,脐带间充质干细胞组治愈率及治疗有效率均高于常规治疗组,脐带间充质干细胞组起效的平均时间及治愈的平均时间均短于常规治疗组。
✔ 类风湿关节炎
类风湿关节炎是一种高度致残的自身免疫性疾病,发病十年的患者中至少有50%的人失去劳动能力。

类风湿关节炎©Health Same of Flickr
我国国内多家医院已开展了干细胞治疗类风湿性关节炎的临床研究。首例自体干细胞移植治疗类风湿关节炎在北京协和医院完成。经过5个月随访,这些经常规药物治疗失败且病情发展迅速的患者,在接受干细胞移植治疗后,症状获得改善,关节肿胀消失,各项检查指标恢复正常。

世界第一例自体骨髓干细胞治疗红斑狼疮由意大利科学家首创。
2007年,我国孙凌云教授用间充质干细胞治疗2例难治性红斑狼疮获得成功,次年又收治了9例患者。经过治疗后,患者症状明显缓解,随访6个月未见复发。
2013年,长江大学附属第一医院和荆州市第一人民医院风湿免疫科为18位系统性红斑狼疮患者肘前部静脉输注脐带间充质干细胞。1个月后,大多数患者发热、疲倦、乏力等临床症状及体征较移植前得到明显改善。
3、心血管系统疾病
✔ 左心发育不良综合征
2016年11月28日,在马里兰大学医学中心的手术室中,患有先天左心发育不良综合征(HLHS)的Josue接受了间充质干细胞的注射,利用干细胞的分化作用,增加心肌细胞,修复了受损的心脏。接受手术后,Josue的状况稳定,他的父母非常开心。

✔ 下肢静脉溃疡
2016年,70岁的陈女士因右下肢静脉溃疡引发慢性创面,辗转治疗近9个月都无法愈合。中国工程院院士,我国著名的创伤和组织修复与再生医学专家付小兵教授应用脐带间充质干细胞治疗新技术,对陈女士的慢性创面进行治疗。55天后,陈女士的伤口完全愈合,治疗效果明显。
4、代谢疾病
(1)糖尿病
目前临床上尚无根治糖尿病的方法,只能依赖体外给予胰岛素或药物降低血糖,同时配合饮食调理和运动。

在我国,已有三甲医院开展了间充质干细胞移植治疗II型糖尿病的临床研究。大多数患者都达到血糖降低,胰岛素减量的效果,部分患者甚至停止用药。与此同时,患者体质增强了,亚健康状态也得到一定程度纠正。
(2)糖尿病并发症
间充质干细胞在糖尿病并发症上的应用前景更为广阔。
✔ 糖尿病足
陕西省人民医院在无菌条件下,为5位住院的Ⅱ型糖尿病并发糖尿病足患者按3cm×3cm间距于患处多点肌内注射脐带间充质干细胞悬液,病变严重者足部按1cm×1cm间距注射,溃疡周围重点注射,治疗后足部疼痛和麻木程度明显减轻,间歇性跛行显著改善,溃疡全部愈合。

✔ 糖尿病肾病
第二军医大学福州总院临床医学院与第二军医大学附属长征医院向15位胰背动脉、双肾动脉介入及外周静脉输注脐带间充质干细胞,治疗后,患者血压、血糖、C 肽值及肾功能指标均有所改善。在改善舒张压、肾功能方面的临床疗效方面,治疗组优于皮下注射胰岛素的对照组患者。
✔ 糖尿病视网膜病变

武警总医院在9位糖尿病视网膜病变患者的下睑眶缘外中1/3交界处垂直注入脐带间充质干细胞,术后1个月,2号患者眼视力提高0.5,出血灶、渗出基本完全吸收;8号患者眼视力提高0.3,出血灶、渗出有所吸收,微血管瘤数减少;5号患者眼视力提高0.2,出血灶、渗出略有吸收,无新鲜出血。
5、神经系统疾病
✔ 帕金森病

我国第一例干细胞移植治疗帕金森病在石家庄医院完成。来自印尼的76岁老人谢喜云患帕金森病十几年,右手三个手指肌肉强直收缩,身体僵硬,吞咽困难,失去生活自理能力。在接受间充质干细胞移植后几个小时,就能顺利进食,当晚还能轻松地观看电视节目,身体其他症状明显好转。
中国医科大学的孙丽博士将含有脐带间充质干细胞的悬液通过颈动脉植入10位帕金森病患者体内,患者移植后,行走姿势、震颤程度,自主运动及坐、起运动能力得到提高,不但有效控制帕金森病的发病进程,而且有效改善受损的脑组织功能,提高了患者生活质量。
✔ 老年痴呆
贵阳市金阳医院周强和他的团队,用自体骨髓干细胞先后治疗了四位老年痴呆患者。首例患者是一位75岁的男性,入院时不认识亲人,大小便不能控制。移植治疗后以上症状迅速改变,出院时,不但能认知家人,大小便也恢复正常。
✔ 肌萎缩侧索硬化症
冰桶挑战赛让我们认识了“渐冻人”(肌萎缩侧索硬化症,ALS)患者。北京武警总医院收治了47例ALS患者,有22人在移植干细胞后机体功能获得改善,其中8人尤其明显。一位患者李女士刚入院时言语不清、上肢乏力、下肢抬举困难,治疗后可以迈开双腿走路。安沂华主任对住院接受脐带间充质干细胞治疗的99位ALS患者进行了疗效分析,发现脐带间充质干细胞移植可以改善ALS患者的运动功能,在短期内效果较好,整个过程是安全的。
✔ 脑瘫
解放军463医院的吴景文、王金刚等专家使用脐带间充质干细胞对近200例脑瘫患者进行了治疗,结果显示都是有效。治疗4周后,患儿粗大运动功能均有不同程度的改善,其中仰卧位与俯卧位、坐位、爬与跪、行走与跑跳功能经统计学分析具有显著性意义。出院后6个月至1年,患儿粗大运动功能仍然有不同程度的改善,肌张力明显降低。
✔ 失眠症
浙江武警总队医院的王亚莉医生为19位失眠症患者静脉输注脐带间充质干细胞治疗慢性失眠,这些患者均入睡困难,睡眠质量下降,总睡眠时间不到6小时。移植治疗后1个月,患者的睡眠改善作用同口服药物相当;治疗2个月后,患者的睡眠质量评分明显好于口服药物,治疗3个月后,患者的睡眠质量也明显优于口服药物,且一次治疗作用可持续达1年之久,患者睡眠质量改善显著。
6、消化系统疾病
✔ 肝硬化

2005年,我国第一例干细胞移植治疗肝硬化在北京军区总医院完成。42岁的河南患者邢先生到医院就诊时已经全身黄疸,肝腹水,生命岌岌可危。医院的姚鹏主任用一根导管通过股动脉,把自体干细胞悬液送到患者肝脏。一周后,患者状态明显转好,腹水消失,能进食了,走路有劲了。5个月后到医院复查,黄疸指数等八项生化指标全部恢复正常,原先已经萎缩的肝脏竟长大了一圈。
如今国内已有数千例肝硬化患者从间充质干细胞移植中获益。
7、运动系统疾病
✔ 股骨头坏死
间充质干细胞移植治疗人体股骨头坏死在国外已有报道。法国科学家移植治疗116例股骨头坏死患者效果显著,其中87.3%的患者髋关节疼痛缓解;78.4%的患者关节功能改善;80%的患者行走间距延长。
吉林一位许姓小伙在一次攀岩活动中从高处摔下来,送到医院检查,双侧股骨头已坏死变形。按照常规治疗方法,应行人工关节置换手术。可是人造股骨头的寿命一般在10-15年,小许才27岁,一辈子需要不停地更换人工关节。
沈阳463医院的杨晓凤主任将间充质干细胞经过技术处理后注入小许的股骨头,两周后小许就可以下地行走了。10个月后,小许来医院复查,他的股骨头周围已长出丰富的血管,表明移植的间充质干细胞促使坏死变性的股骨头修复新生。

脐带MSC治疗股骨头坏死的临床研究结果
✔ 退行性关节炎

20世纪90年代,Brittberg等开始利用自体软骨细胞修复软骨损伤取得了一定效果,因此越来越多的研究开始关注间充质干细胞。间充质干细胞可以分化为各种组织,修复关节表面软骨和软骨下骨损伤。
8、泌尿生殖系统疾病
✔ 不孕不育

子宫内膜受损严重,是很多不孕不育女性的噩梦。现在通过间充质干细胞再生技术修复子宫内膜,可重圆女性的母亲梦。
南京鼓楼医院妇产科胡娅莉教授团队与中国科学院遗传与发育生物学研究所联手,首次在国际上成功研制出胶原支架复合间充质干细胞的方法,结合传统宫腔镜技术,实现了受损子宫内膜的功能性修复,帮助3名患者实现做妈妈的梦想。
江苏盐城的胡女士在31岁到34岁时,经过三次自然流产,因为流产清宫手术,子宫腔严重粘连。南京鼓楼医院利用间充质干细胞8个月修复了她的子宫内膜,使她成功怀孕,并于2014年7月17日诞下了国内第一位“再生医学宝宝”。
间充质干细胞“子宫内膜再生”术已先后让13位重度子宫腔粘连致不孕的患者成功受孕并分娩,共计诞生14名健康的“再生医学宝宝”。
✔ 勃起功能障碍
运用干细胞治疗勃起功能障碍一方面可以完全取代受损和死亡的阴茎组织细胞,另一方面可以分泌一些因子修复功能受损的阴茎组织细胞。
丹麦15位勃起功能障碍患者在未接受药物或阴茎移植术的情况下接受间充质干细胞的输注,6个月后,8名男性能够正常性交。
9、抗衰老
人体的衰老与干细胞相对数量不足或活性不足有关。随着年龄的增长,干细胞在体内的数量和质量呈现下降趋势。这种趋势导致受损的细胞和由细胞组成的组织器官出现衰退和老化,导致亚健康和衰老现象的发生。间充质干细胞具有多向分化潜能,能够分化成体内急需的各种干细胞,补充体内干细胞的不足,修复受损的器官和组织,从而起到抗衰老作用。
10、细胞组织工程
壁虎和蝾螈断了尾巴能重新长出来,缺了四肢有新的替补,人类只能借助再生医学手段进行缺损组织器官的修复。
种子细胞是器官再生的物质基础,以脐带间充质干细胞为种子细胞进行体外扩增培养,然后放在特殊的生物材料中使其生长,最后移植到人体病损部位,可望实现创伤的完美修复。
随着对脐带间充质干细胞研究与应用热度的持续升温,相信在不久的将来,它必然广泛应用于临床,为人类健康发挥更大的价值。
医家园健康管理平台

医家园
精准 - 快速 - 全面
北京市朝阳区丰联广场
免责声明:我们尊重原创,也注重分享,如有侵权,请及时联系我们会立即做出处理。



